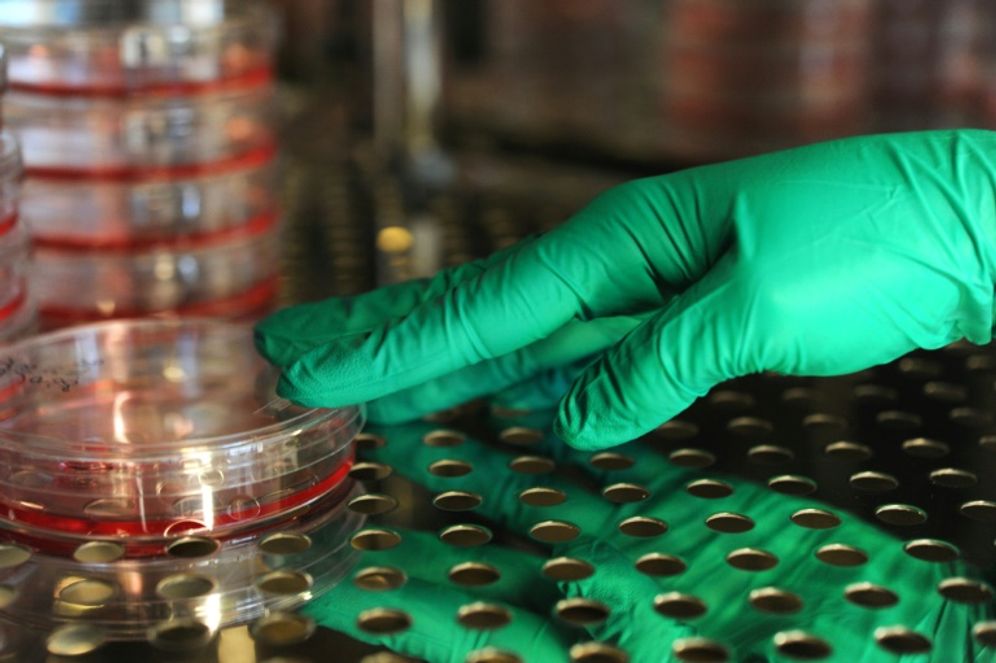

Israël: un traitement pour soigner le cancer du pancréas en 14 jours
Injectée par voie intraveineuse, la molécule PJ34 entraîne l’autodestruction des cellules cancéreuses

Un nouveau traitement mis au point par des scientifiques de l'Université de Tel-Aviv pourrait détruire les cellules cancéreuses du pancréas jusqu'à 90%, après deux semaines d'injections quotidiennes de la molécule PJ34, rapporte le Jerusalem Post.
Ce traitement pourrait constituer une réelle avancée pour les malades atteints du cancer du pancréas, qui en général, ne vivent pas plus de cinq ans après l'annonce du diagnostic.
La recherche, dirigée par la professeure Malka Cohen-Armon et son équipe de la faculté de médecine de l'Université de Tel-Aviv, en collaboration avec l’équipe de la Dre Talia Golan du Centre de recherche sur le cancer du Centre médical Sheba, a récemment été publiée dans la revue biomédicale Oncotarget.
Lorsque la molécule PJ34 est injectée au malade par voie intraveineuse, elle entraîne l’autodestruction des cellules cancéreuses au cours de la mitose (division d'une cellule mère en deux cellules filles strictement identiques génétiquement).
Le traitement a été testé sur des souris pendant un mois, mais après seulement 14 jours d'injection, il a été constaté "une réduction de 90% des cellules cancéreuses", a déclaré Cohen-Armon au Jerusalem Post.
"Chez une souris, la tumeur a même complètement disparu."
"Cette molécule (la PJ34 NDLR) provoque une anomalie lors de la division des cellules cancéreuses, provoquant une mort cellulaire rapide," a-t-elle déclaré.
En revanche, la PJ34 ne semble oas avoir d'impact sur les cellules saines, c'est pourquoi "aucun effet indésirable n'a été observé."